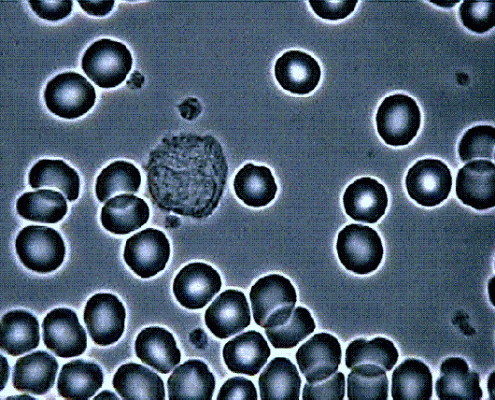

O PONTAL ENERGÉTICO TRABALHANDO A CONVERSÃO DE VALÊNCIAS DOS ENDOBIONTES
– O Pleomorfismo e a interface sutil com o Pontal Energético
“Cada partícula, física ou sutil, que compõe
ora o nosso corpo ora outros corpos
é tão antiga quanto o próprio universo “.
Cosmo Rtc
Este estudo baseia-se nas pesquisas iniciais do Dr. Gunther Enderlein e nos estudos das análises de microscopia de campo escuro. O Dr. Enderlein estabeleceu na década de 30 o estudo da ciclogenia bacteriana denominada de “pleomorfismo”, o qual, estuda uma “nova” abordagem sobre as bases da medicina convencional quanto à teoria anatomoclínica (teoria celular e teoria de germe), cuja base ainda é o monoformismo, onde a espeficidade e as afinidades do germe são enfoques químicos e não biológicos, portanto, dando uma abordagem totalmente química do germe.
Já o Pleomorfismo está sob a visão da teoria pleomórfica, que considera e valoriza a interação dos seres vivos entre si, bem como, suas vidas em seu “habitat” uma vez que a interação com o meio, determina fatores genéticos (fenogenotipia). No pleomorfismo é admitida a mudança de forma além dos limites da espécie: “trans-espécies”.
– Algumas teses do Dr. Enderlein:
- “Os microorganismos apresentam mudanças características de vários estágios de desenvolvimento (ciclogenia), indo da forma coloidal à forma de culminância”.
- “A virulência do microorganismo é determinada pela sua fase de ciclo (cicloestágio) e não pelo seu material genético”.
- “A esterilidade do sangue, tanto em filtrados quanto em centrifugados é um postulado falso da ciência oficial. Os elementos sangüíneos de todos os mamíferos, mesmo os saudáveis, apresentam infestações maciças de Endobiontes em fase primitiva”.
- “O equilíbrio dos endobiontes (simbiontes) é alterado pelas mudanças do meio, principalmente o pH, levando-os às fases evolutivas (ciclode) e expressivas de condições clínicas de anomalias”.
- “As doenças estão relacionadas com os distúrbios dos Endobiontes e são denominadas como Disbioses”.
- “A cura se dará na proporção em que se constate uma regressão dos Endobiontes às fases mais primitivas. Não está condicionada ao desaparecimento do microorganismo”.
- “Não é a célula e sim o colóide protéico a menor forma de vida. Ele já contém em si uma dinâmica vital. É na verdade matéria viva com vínculo teleológico”.
- “Os germes reproduzem-se sexuadamente”. Enderlein identificou em todos os micro-organismos que estudou, dois tipos de reprodução: a reprodução assexuada por divisão celular “Auxa-nogênica” e sexuada “Probaenogênica”.
- “A fibrina é um sedimento de coagulação de proteínas provenientes do metabolismo endobiôntico”.
- “Os trombócitos (plaquetas) não são células e sim Técitos dos Endobiontes”.
- “Os megacariócitos não são objetos celulares normais e sim infestações maciças de Endobiontes em estágio primitivo que perderam a capacidade de se replicar”.
- “Os Normoblastos e Eritrócitos da MO não têm núcleos, mas, tão somente um “pseudonúcleo” de colônia de Endobiontes do estágio Condrite”.
- “Os macrócitos são Eritrócitos aumentados sem pseudonúcleo”.
- “A granulação periférica dos Eritrócitos não são Organelas (Schilling), e sim Simprotites dos Endobiontes”.
- “Os Reticulócitos não são Eritrócitos com Organelas especiais e sim Eritrócitos infestados por Condrites”.
- “Os pseudópodes dos Leucócitos são a evidência da formação do Condrite-Dendróides”.
- “A causa da infectividade dos filtrados de tuberculose é a presença do bacilo da Tuberculose no estágio Condrite”.
- “Ao longo de sua evolução, o Ser Humano desenvolveu uma simbiose básica com dois fungos: o Mucor Racemosus e o Aspergillus Niger”.
- “A forma culminante do Mucor Racemosus pode ser cultivada a partir de material de tumores”.
– Interferência freqüêncial do Pontal Energético nos Endobiontes.
O presente estudo que proponho, é a existência de interface de atuação das freqüências sutis emitidas pelo Pontal Energético e a possibilidade de interferência destas freqüências sutis em microorganismos pleomórficos, revertendo as valências de tais microorganismos, ou seja, na ciclogenia dos endobiontes.
Os endobiontes não morrem, não sofrem a ação do tempo não tem processo dissipativo, eles vivem e se movem em função de campos de freqüência, logo, a tese de interferência freqüêncial pode se mostrar positiva com o uso do Pontal Energético.
Veremos isto mais adiante.
Claro que para tal utilização é necessária uma “tecnologia” igualmente sutil, onde a radionica pode ser uma grande ferramenta de entendimento de usabilidade do Pontal. É importante, entretanto, entendermos um pouco mais sobre os endobiontes, o que são, como se transmutam, como se desenvolvem e qual o papel que eles exercem nas doenças, quando se transformam em bactérias, fungos ou vírus.
Os endobiontes (nanobactérias), quando se juntam por atração de polaridades aumentam sua valência e se transformam em diversos “seres” com ciclogenia, ou melhor, ciclos de crescimento ou desenvolvimento em até 25 características diferentes, iniciando em uma fase regulatória e indo até a fase degenerativa quando são encontrados em exames de microscopia de campo escuro. Encontramos diversas formas diferentes de “seres”, que nos permitem identificar o estágio de desenvolvimento de determinada patologia, por exemplo, nanobacterias como Sinácitos, Técitos, Simprotites, etc.
Na verdade, os endobiontes tratam-se de ARN mensageiros, seu processo de criação se dá através de fótons cósmicos que atravessam a membrana celular e são “oxidados”, eles se convertem na mitocôndria (interface mutacional) e são liberados na corrente sangüínea como “protites”, ou seja, endobiontes de menor valência, que também podem ser chamados de colóides. Logo, podemos entender que os elos entre os fótons de luz e a vida são estes colóides, portanto, as doenças, como entidades nosológicas, além de arquetípicas sã sínteses informativas de natureza genética, expressas sob a forma de um código depositado no citoplasma celular por um ácido nucléico (ARNm).
A cada doença corresponde um código ARN específico e para evitar a má execução das instruções codificadas, o ARN mensageiro exerce também o papel de enzima catalizadora das reações químicas necessárias ao desenvolvimento da patologia “ressuscitada da memória arquetípica” de onde provem as instruções detalhadas e necessárias ao seu desenvolvimento patológico.
As doenças são como entidades “nosológicas”, quando a pessoa está doente os colóides produzidos são colóides relativos a ela, logo, a doença é uma adaptação a determinada situação de terreno onde se desenvolverá o endobionte.
O terreno a que me refiro é a própria alimentação das pessoas, seu estado físico, mental e espiritual, além claro, das ondas de radiação ionizantes ou não ionizantes, as quais, atuarão diretamente no ARNm, ou seja, no colóide protite. Entretanto, a principal forma de terreno é a forma de pensamento, gerando ondas de freqüências mentais que podem propiciar uma substancial força de atração dos protites (colóides) e em seguida acelerar os estágios de valência, em forma de endobiontes para a ciclogenia da bactéria, onde os protites se evoluem para endobiontes, assumindo a forma de simprotites e se reproduzem quando se formam os miquitos que por sua vez infestam os eritrócitos, promovendo uma divisão nuclear, que ao saírem dos eritrócitos infestam todo sistema sangüíneo com novos seres, como o “fila”, e seqüencialmente para condrites, acites e finalmente os sinacitos.
O ambiente/terreno é, portanto, o fator primário preponderante que controlará a valência dos microorganismos no corpo. É fato também que microorganismos entram e tomam posse do corpo pelo ambiente externo (exógeno). Quando os tecidos estiverem em um estado de acidoses (estado produzido pelo aumento de ácidos no organismo já descrito acima), o corpo geralmente é infestado com endobiontes patogênicos que debilitam a resposta imune a invasores do ambiente externo, por ser o ambiente interno acidótico um potente ativador bacteriológico.
A fase avançada de desenvolvimento dos endobiontes para parasitas (mucor racemosus, etc) também fluem de suas próprias espécies de ácidos específicos que compõem o problema de acidoses. Assim, o corpo sempre é ameaçado com a possibilidade de infecção destes sempre-presentes companheiros de milhares de anos, se o ambiente do Ph é alterado a valores decrescidos, (o Ph ideal para o sangue é de 7,325 ). Quando o organismo percebe o fungo, que é em sua essência alcalino, o organismo naturalmente acidifica o sangue e daí o meio de desenvolvimento de valência de inúmeros endobiontes é acelerado, transformando os endobiontes em bactérias, fungos ou vírus.
As sementes (microorganismos) já estão no organismo (endógeno). Isto é, o corpo é o anfitrião de microorganismos de origem exógenos e fases avançadas de origem endógenos estritamente baseado nos valores de Ph que existem no organismo. Sendo assim, terapias de reeducação ambiental, alimentar ou sutil (alternativas ou complementares) sempre são de suma importância ao lidar com infecções.
A alcalinização, como correção da acidose sanguínea, às vezes é suficiente para eliminar os microorganismos exógenos, como suas exigências de Ph são específicas.
A simples mudança de ondas mentais (elétrons mentais) ou a regularização de Ph promovido pelo alimento adequado pode indubitavelmente reverter valências destes endobiontes. Provavelmente aí resida alguns casos comprovados de melhorias impressionantes em estados patogênicos endêmicos pelo fato da pessoa atendida passar por sessões de energizações com o Pontal Energético, potente emissor neutrínico, ou mesmo tomando a água frequencializada, uma vez que a água “energizada” ou potencializada neutrinicamente, absorve uma freqüência sutil determinada, (principio Homeopático de Hahnemann) relativa a ondas geradas pela piezeletricidade do cristal que está acoplado à base de metal, que ao que tudo indica afeta o desenvolvimento de valências de endobiontes.
Não sabemos exatamente como este processo é realizado a nível de microorganismos, mas, podemos depreender ou intuir que se trata de uma conseqüência puramente vibracional, onde a vibração do Pontal Energético atua de forma sutil sobre tais endobiontes e mesmo sobre o próprio Protite, interferindo, por ressonância freqüêncial sutil no processo de start de valência ciclogênica dos endobiontes. Do ponto de vista energético, poderíamos considerar que a título de exemplo, uma pessoa com resfriado vibra em uma freqüência diferente da qual ele está normalmente sintonizado (300 Hz). Imaginemos que a freqüência na qual esta pessoa vibra, quando está tentando livrar-se do resfriado seja de 475 Hz, se esta pessoa for capaz de produzir mais energia no nível de 475 Hz isto muito provavelmente permitirá livrar-se deste resfriado com mais rapidez, tal princípio se vale das ondas semelhantes que se neutralizam. Desta forma, tais ondas emitidas sutilmente pelo Pontal Energético neutralizariam as valências por permitirem um ajuste a um comando mental destas ondas em direção à pessoa atendida.
Estas freqüências sutis estariam situadas em uma interface física/astral entre 2.5 Khz até 900 Hz, ou mais, emitidas pelo Pontal Energético, onde os “elétrons mentais” produzidos pelo campo mental do operador são extremamente mixados pelo Pontal Energético. Essas potencializações atuam como chaves sutis, iniciando vários starts em relação à energização da pessoa atendida. É importante notar que em nossas pesquisas observamos a necessidade de um procedimento padrão onde a orientação, o foco e o conhecimento da patologia a ser atingida vibracionalmente é de fundamental importância, como se houvesse um “mapa” para se chegar a um local, quero dizer que é de fundamental importância que a mente do operador do Pontal, quando usado terapeuticamente em reversão de ciclogenias bacterianas, saiba exatamente qual o problema, quais os endobiontes, para que as freqüências sutis sejam enviadas com “coordenadas específicas” ampliando desta forma enormemente a resposta profícua ao tratamento complementar, para se saber qual a valência de tais endobiontes para o tratamento vibracional é fundamental a realização do exame de microscopia de campo escuro.
O Instituto Holístico de pesquisas radionicas dispõe de cursos para que estas técnicas de utilização do Pontal sejam estabelecidas, bem como um protocolo de atuação.
O Pontal Energético tem neste ponto sua maior e mais importante missão dentro do campo de saúde holística. A geração destas oscilações sutis pode ser, a principio, captada pelo sistema parasimpatéticos, pois, ao emitir freqüências sutis que teriam um comprimento de onda idêntica (bio-eletrônica idêntica) ao do patógeno, tais ondas poderiam desfazê-los, conforme exposto acima.
Quando as freqüências sutis do Pontal Energético são corretamente programadas e atingem os endobiontes com a mesma vibração que lhes são características, existe uma grande possibilidade de que tais endobiontes se desfaçam por quebra da sua estrutura. Como estamos falando de nano partículas, estas partículas são extremamente sensíveis às freqüências, sejam elas oscilatórias ou sutis.
Apenas para elucidar, o quanto as ondas de freqüência são importantes quando se trata de bactérias, vamos analisar a seguir alguns dados: sabemos que algumas bactérias também são muito sensíveis à fotoluminescência, ou a comprimentos das ondas Ultra Violeta, o que tornam tais ondas fotônicas igualmente bactericidas. Senão, vejamos pelo menos parte destes fenômenos bactericidas das Ondas Ultra Violetas e como podem ser explicados por dois aspectos:
Primeiro: as células do corpo são imensas quando comparadas às bactérias; Segundo: determinadas bactérias contêm significativas quantidades de dois aminoácidos fotossensíveis, fenilalanina e Tirosina, que são quase ausentes nas células do corpo. Devido à sua foto-atividade, estes aminoácidos levam as bactérias a absorver quantidades maiores de ondas Ultra Violeta, tal absorção de energia UV inicia um processo de coagulação que destrói a bactéria. Como as células do corpo são muito menos fotossensíveis, elas não são afetadas.
Seguindo o mesmo princípio da fotoluminissência, onde as ondas fotônicas atuam em bactérias, por analogia, podemos supor que o mesmo ocorre quando ondas sutis podem destruir tais bactérias. Qualquer outro meio hábil e sutil que é empregado paralelamente, como frequencializações pelo Pontal energético ou zapper, quando aliadas com terapias de ambiente e alimentares também são úteis e importantes. Mas, onde ocorre o fracasso em tais processos, os resultados podem ser candidíase, viroses, etc…
Relacionamos a causa das patologias às bactérias e não aos microorganismos (endobiontes), que na verdade são os precursores das doenças. De que adianta extrair a erva daninha se você não conseguir arrancar a raiz?
A informação original das patologias, ou seja, os microorganismos, aumentam sua valência e o poder de infecção de acordo com a recaída da freqüência emocional da pessoa proporcionando desta maneira a desajuste de Ph. É assim que se inicia o processo no qual o sangue está se acidificando ou alcalinizando. Veremos a importância deste ponto quando analisarmos adiante a importância do sistema nervoso central no processo de descontrole do Ph.
Como já vimos anteriormente é possível, “a princípio” a interferência no Ph sanguíneo com alguns remédios vibracionais criados com o Pontal Energético através de freqüência sutil, porém, para a realização deste processo seria indispensável o conhecimento de manuseio do Pontal Energético, que estão disponíveis através de cursos ministrados no Brasil pelo Instituto de Pesquisas Holísticas Pontal Energético.
A eficácia da interferência destes remédios vibracionais é alcançada quando se atua na área da informação mental (hipotálamo), tanto do corpo quanto da própria mente e quais os padrões originais para a provocação de determinados hormônios peptídeos (açúcares) e demais componentes de síntese catalisadora que estão intimamente ligados com o Ph.
Também não podemos nos esquecer que os próprios microorganismos (endobiontes) liberam suas próprias espécies através de ácidos específicos, portanto, qualquer coisa que os reduza às valências de patogenicidade ou sua ciclogenia em fases inversas de desenvolvimento também contribuirão para redução de acidoses.
Neste ponto o Pontal Energético pode, teoricamente, atuar como “reversor” de freqüências específicas, proporcionando à principio uma correção sutil tanto da acidose quanto da alcalinidade. Desta forma uma grande possibilidade de reversão ciclogênica dos microorganismos estará sendo promovida.
No momento em que a freqüência mental da pessoa atendida for acionada através do Pontal Energético pelo terapeuta complementar que está lhe atendendo, bem como, a energização da água em um copo, uma série de informações serão recebidas pelo hipotálamo da pessoa que enviará mensagens para o importante sistema regulador do corpo: o sistema endócrino, o qual, controla, os mecanismos físicos e químicos envolvidos no metabolismo e assim as freqüências variantes de reações químicas dentro de cada uma de nossas células. Portanto, depois de alguns minutos após ser ingerida tal água frequencializada pelo Pontal, uma provável normalização da acidose também pode ocorrer porque estes mensageiros químicos-sutis (elementos vibracionais) captados pela água circulam por todas as partes do corpo e afetam determinados endobiontes alvo capazes de se desfazerem diante da freqüência idêntica. Sendo assim, estes dois sistemas teoricamente erradicariam ou inverteriam os endobiontes – alvo do sistema a ser trabalhado.
O conhecimento da Radiestesia pode ajudar uma melhor compreensão do funcionamento sutil do Pontal Energético nas situações acima expostas. Portanto, a Radiestesia poderá confirmar os campos teóricos de pesquisa relacionada ao Pontal Energético. É na verdade uma ferramenta de aprendizagem comprobatória, pois, ainda não temos equipamentos para a detecção de freqüências tão sutis. Entretanto, elas se tornam verídicas quando ao se estudar algumas lâminas em microscópio de campo escuro pode se observar a reversão ciclogênica acima citada. Como isto ocorre? A esta pergunta não temos resposta, apenas evidências conforme estudos anteriores.
Seria preciso estudos mais profundos e talvez quânticos para a identificação correta desta interação, entretanto, uma provável hipótese é a resposta dos protites, diprotites e triprotites que teoricamente seriam extremamente sensíveis às freqüências de campos piezelétricos, transmutando as suas próprias polaridades e daí, o fator ressonância amplificadora do Pontal Energético poderia interferir diretamente de forma exógena, pela emissão de freqüências, nas fases evolutivas dos endobiontes tanto em sua valência, enquanto endobiontes, bem como, formações mais complexas, como por exemplo, condrites, ascites e sinascitos e daí para bactérias, fungos ou vírus, que ocorreria endogenamente.
Notamos que o estado mental da pessoa atendida terapeuticamente é preponderante no resultado eficaz do Pontal Energético, portanto, ele estaria diretamente ligado às respostas do hipotálamo, como já discutimos e veremos a seguir.
O uso do Pontal Energético é no mínimo um importante meio de complemento para que a pessoa possa obter um estado de saúde e vitalidade emocional mais ajustado ao ambiente, à natureza e à ecologia de todo o sistema “Self”.
Temos como importante aliado as últimas pesquisas no campo da inteligência emocional, onde, a forma-pensamento constrói a realidade comportamental do ser.
Um ponto muito interessante é que o Pontal Energético parece trazer uma resposta mais profícua quando a pessoa atendida pela terapia complementar, já utiliza e é simpatizante de produtos como Florais de Bach, acupuntura, cromoterapia, cristaloterapia, musicoterapia, Reiki, meditação entre outras formas complementares de tratamento, o que demonstra que as pessoas que se utilizam de processos ditos transcendentes se afinam com maior facilidade e são totalmente receptivas às freqüências sutis emitidas pelo Pontal Energético, onde parece haver um entendimento “prévio”, dos protites ou mesmo dos endobiontes neste processo. Como os protites são na verdade como ARN mensageiros, a idéia é que eles teriam como informar sobre campos de freqüências intrusos, benéficos ou não às demais valências.
O uso do Pontal Energético, mesmo que ocorra ocasionalmente, é um grande meio de complemento, onde a pessoa que está sendo atendida pela terapia do Pontal acaba sentindo “fisicamente” uma energia complementar no tratamento. O Pontal Energético é um importante meio de conexão entre o hipotálamo e a glândula pineal (cujas glândulas são compostos cristalinos que ressonam com a freqüência do Pontal Energético) regularizando o sistema parassimpático e simpático em si, regulado pelo sistema nervoso autônomo. Logo, este sistema endócrino sustentado pela pituitária posterior, cuja qual trabalha glândulas mamárias e rins, e a anterior trabalham peito, músculos, ossos, tireóide, pigmentação cutânea, ovários, testículos e córtex supra renal, nos trazem as seguintes interações e resultados do Pontal Energético, possivelmente, amplificando todo o sistema da seguinte forma:
– No sistema parassimpático as freqüências geradas pelo Pontal Energético podem beneficiar por ressonância, ao menos mentalmente, a pessoa nos seguintes pontos:
- equilíbrio hídrico, equilíbrio energético, equilíbrio de crescimento e maturação, bem como, da circulação e respiração.
– No sistema simpático poderemos obter as seguintes interações do Pontal Energético quando mentalizados e programados:
- Melhora na fisiologia reprodutiva, equilíbrio da atividade motora e do sono, bem como, da temperatura do corpo, do sistema imunológico, da pressão arterial, possível controle de crescimento tumoral em função da reversão ciclogênica acima descrita. As freqüências do Pontal Energético também podem incidir sobre as supra-renais, o pâncreas, a pituitária, a tireóide e indiretamente o timo. Possivelmente, desta forma, pode regular o envelhecimento garantindo uma maior longevidade.
Todos os sistemas do corpo se intercomunicam em um constante estado de fluxo de informações oscilatórias centralizado pelo hipotálamo, portanto, o hipotálamo se interconecta entre mente e corpo coordenando a rapidez e a capacidade de ambos afetando nossa consciência e deste modo controlando o constante estado de alerta, prevenção e preparação. Tal conservação vibracional, extremamente sutil, desta harmonia do organismo é efetuada quando se sincronizam as funções vitais do corpo com as condições ambientais unificando-se com o universo. É exatamente neste momento que ocorre a interface de atuação vibracional do Pontal Energético.
O Pontal Energético pode ser um poderoso recurso profilático quando adequadamente freqüencializado e também um poderoso medidor de respostas radionicas, quando o terapeuta requisitar informações sobre determinado quadro, tanto patológicos quanto da patogenia a ser estudada. O Pontal, então, pode ser usado tanto para frequencializar, produzir florais, intensificar terapias e também como um aparelho radionico de consultas tanto da patogenia quanto da patogenicidade, pois, certamente tais respostas ajudarão muito os terapeutas que trabalharão com o Pontal e serão muito úteis para que ocorra uma efetiva potencialização dos medicamentos alternativos produzidos pelo Pontal, tendo como base as informações dos quadros sanguíneos estudados acima, como informações adicionais em relação à pessoa atendida.
Também é possível, utilizando o Pontal Energético radionicamente, uma provável resposta mais acertada do nível de stress que a pessoa a ser atendida se encontra, e quais as freqüências mais indicadas no tratamento proposto, bem como, se tal potencialização deverá ser feita com florais, homeopatia ou produzida pelo próprio Pontal, pois, o corpo gera uma freqüência particular e específica que pode ser captada radiestesicamente pelo Pontal Energético através de informações quase sempre precisas, promovendo respostas ajustadas para atuação de cada patologia.
A água magnetizada pelo Pontal Energético difere da maioria dos florais existentes e mesmo de alguns homeopáticos, seu princípio é inteiramente energético e sutil e a proposta é a replicação, por freqüência, de microorganismos “sutis-identicos” virtuais de menor valência, ou seja, é a criação “virtual” destes microorganismos na água com o propósito de reverter a ciclogenia, logo, ao criar-se virtualmente microorganismos de valências cada vez menores, os de valência maiores se extinguem naturalmente.
Em recentes estudos, observamos a enorme diferença entre duas bromélias quando foram submetidas à irrigação, uma normalmente e outra com a água frequencializada pelo Pontal.
O resultado foi surpreendente, em 21 dias observamos um crescimento três vezes maior da planta quando irrigada com a água do Pontal Energético. Provavelmente o Pontal Energético de alguma forma interferiu nos componentes celulares portadores da clorofila dentro das células da bromélia, ou até mesmo interferiu no gene da planta, alterando desta forma toda sua estrutura celular. Logo, a interferência nos cloroplastos teriam modificado-os e começaram a se duplicar ou triplicar o padrão de crescimentos resultando na bromélia maior, como pode ser vista no site www.pontalenergetico.com.br.
Finalmente, acreditamos que este processo ocorrido com a bromélia é um fator comprobatório importantíssimo para validar toda a teoria aqui exposta de interferência vibracional do Pontal Energético, o qual, nos parece como um processo informacional, ou seja, de informações vibracionais que atingem sistemas à nível celular e à nível de microorganismos.
Considerando que este é verdadeiramente um processo informacional, seria uma experiência quase imprescindível fazer potencializações ou energizações equivalentes com o uso do Pontal Energético, tanto em situações patogênicas como, no caso da Bromélia (de desenvolvimento imunológico) quanto de outras fontes de melhoria da saúde geral, como forma profilática de melhora geral de saúde. Lembrando que em hipótese alguma o Pontal Energético substitui medicamentos ou metodologias médicas que as pessoas estejam usando, ele é apenas uma terapia complementar, ou seja, um coadjuvante em qualquer tratamento.
Esta lógica de informações, entre os microorganismos ou interferência no gene do DNA sofrem certamente influência informacional virtual, possivelmente uma “inteligência microrgânica” esteja instalada na teia sutil dos microorganismos, logo, são informações que interagem, de alguma forma oscilacional, com o sistema límbico (no caso humano) ou no desenvolvimento da planta (crescimento) cuja freqüência é trabalhada vibracionalmente. Desta forma, o nível oscilacional seria ativo “intencional” e não biológico, porém, com respostas biológicas.
Contudo, existe uma inteligência “maior” que se interpõe entre o estilo de vida e as respostas biológicas promovidas pelos microorganismos que somente em pouquíssimos casos não dependem de suas atitudes de vida ou reações que elas tenham em função de suas crenças, isto fica bem claro tendo como base a resposta das pesquisas com a bromélia e mesmo em alguns depoimentos constantes em nosso site.
É interessante sempre mostrar a influência por um processo natural que usa um anfitrião (meio de condução), como ervas, elementos, microorganismos virtuais, água energizada no processo terapêutico do Pontal Energético, pois, embora o ativo intencional necessariamente não seja uma resposta biológica, o mesmo pode se potencializar consideravelmente quando tal ativo intencional é consciente…
Porém, o estilo de vida das pessoas é que determina algumas respostas comportamentais e que por tabela criam um próprio modus vivendi que acaba amplificando enormemente as resposta biológicas ou as invalidando. Este processo pode estar ligado a arquétipos, ou seja, à sua própria cultura e crença de forma que quando uma pessoa está fora do seu meio arquétipo ela passa a desenvolver padrões de pensamento e depois comportamento que gerarão fatalmente a aceleração de valência dos seus microorganismos, um exemplo é quando uma pessoa sofre um grande revés em sua vida. Se esta pessoa for muito rica e seu arquétipo se identificar com este estado por muitos anos, é curioso, mas, todos estes microorganismos se adaptam a este estilo, principalmente nas formas de pensar, vestir e alimentar. Então, quando esta pessoa “perde tudo”, ela terá que se adaptar a novas condições que intimamente não a satisfazem, promovendo, então, uma inadequação do atual estado “quo” em que ela vive. Onde a simples mudança da alimentação, sendo diferente em nutrientes ou mesmo em nutrientes nunca antes absorvidos, geram um stress nos microorganismos, potencializando os endobiontes que por sua vez potencializarão os fungos, bactérias e vírus e desencadearão, fatalmente algumas doenças.
Assim, algumas pessoas são levadas a acreditar que elas são limitadas a um caminho sem alternativas em suas vidas ou é “A” ou é “B”, ou são espíritos negativos que a perseguem ou são karmas sem solução, esquecendo-se que nada no universo é dual e que tudo no universo faz parte de uma única consciência. Mesmo uma partícula com polaridade não é capaz de funcionar ou só no positivo ou só no negativo. A interação não fragmentária é que faz com que tudo ocorra.
A simples compreensão deste ponto, já é um enorme passo na correção da valência de qualquer endobionte e conseqüentemente qualquer doença.
Essa compreensão permite a afirmação de que, em uma abordagem holística quântica possamos compreender que: só a bioquímica quântica, aliada à biofísica quântica, dispõe do conhecimento e da linguagem adequados ao estudo dos mecanismos intracelulares e extracelulares tanto quanto a sua atividade energética quanto a sua função moduladora e principalmente quanto a sua participação intrapisiquica, precursora das doenças.
A função do Pontal Energético é, portanto, provar por resultados holísticos quânticos que os seres são mais do que podem parecer, que há outras dimensões de energia que compreendem e interferem no plano físico, que existe uma interface entre a energia e nano seres e que essa energia sutil também pode ser um imprescindível recurso de cura tanto físico quanto psíquico.
Fonte de pesquisa:
– Nulife Ciências – Microscopia Aplicada Avançada para Avaliação e Correção Nutricional;
– Luz – A Medicina do futuro – Dr. Jacob Liberman;
– Fotoluminescência – Dr. Roberto César Leite.
– Pesquisas de Cosmo Rtc
Glossário:
– Acidose: processo acidótico do sangue.
– Alcalino: processo alcalino do sangue.
– Ascite: estágio de um endobionte.
– Ciclogenia: estágio de ciclos de um endobionte.
– Condrite: estágio de um endobionte.
– Endobionte: são nano bactérias que se desenvolvem de acordo com o terreno sanguíneo pelos hábitos de vida e pensamento.
– Endógeno: substâncias, por exemplo, hormônios produzidos naturalmente pelo organismo.
– Exógeno: são substâncias vindas fora do organismo, por exemplo, hormônios sintéticos.
– Freqüência: oscilações de ondas de som ou luz.
– Hipotálamo: é uma das partes mais importantes do cérebro ela age passando ordens do cérebro para o restante do corpo. O hipotálamo é composto por duas zonas principais – uma zona controla o sistema nervoso simpático e estimula a produção de hormônio, a outra controla o sistema nervoso parassimpático e inibe a produção de hormônio.
Atuando como principal centro de coleta de informação do corpo quanto o seu bem estar, o hipotálamo recebe toda informação externa captada por nossos órgãos dos sentidos e todos os sinais internos do sistema nervoso autônomo assim como o da psique, para uma ilustração apenas funciona como uma enorme central de estação ferroviária, recebendo os trens que chegam com suas variedades de mercadorias e distribuindo-as. Suas principais funções incluem controle do sistema autônomo, equilíbrio energético, equilíbrio térmico, controle da atividade e do sono, da circulação e respiração, do crescimento e maturação e da reprodução do equilíbrio emocional, assim o hipotálamo. Talvez seja única e mais importante unidade do cérebro.
As informações recebidas pelo hipotálamo são também utilizadas pelo controle das secreções da glândula pituitária que desse modo afeta de forma significativa outro importante sistema regulador do corpo: o sistema endócrino, em geral o sistema endócrino controla os mecanismos físicos e químicos envolvidos na completa conservação da vida (metabolismo), assim como as freqüências variantes de reações químicas dentro de cada uma de nossas células, então partindo do hipotálamo informações são passadas para a pituitária e em seguida pelo sistema endócrino que faz com que mensageiros químicos denominados hormônios sejam secretados diretamente no fluxo sanguíneo, uma vez no fluxo sanguíneo esses mensageiros químicos circulam por todas as partes do corpo e afetam determinadas células alvo que são capazes de codificar suas mensagens.
– Microorganismo: é de fato a menor partícula e não a célula.
– Patologia: doença especifica.
– Patogenicidade: origem da doença.
– pH: índice que determina a alcalinidade ou acidez no sangue.
– Pineal: trata-se de uma glândula localizada no centro do cérebro entre os dois hemisférios cerebrais, exercem varias funções como mediadora da luz do corpo, sua função é regulada pelas mudanças de luz ambientais e pelo campo eletromagnético da terra transmitindo ao corpo informação relativa à duração da luz do dia.
– Pituitária: faz parte do sistema endócrino cujo qual é constituído pelas seguintes glândulas: pituitária, pineal, tireóide, paratireóide, timo, supra-renais, pâncreas e gonodas. Muitas vezes a pituitária é chamada de glândula mestra porque controla a maior parte das secreções hormonais regulando suas quantidades assim como procedendo a reajustes constantes a necessidade do corpo. A pituitária se divide em duas partes distintas: a pituitária anterior que afeta a tireóide, o córtex supra-renal, os testículos, os ovários, o peito e o crescimento de ossos longos, músculos e órgãos internos; a pituitária posterior que afeta as glândulas mamarias e os rins. Embora a glândula pituitária exerça um papel muito importante no funcionamento do sistema endócrino, ela não pode determinar quais são os hormônios apropriados ou seus níveis necessários para situações especificas, nas quais o próprio corpo se encontra. Essas importantes escolhas condizentes a quase todas as secreções pituitárias são feitas pelo hipotálamo e devidamente enviadas a pituitária por meio de conexão anatômica direta.
– Profilático: medidas de prevenção quanto à saúde.
– Protit: endobionte de baixa valência.
– Radiestesia: principio de medição de freqüências sutis a distancia.
– Ressonância: encontro de ondas pode ser em htz ou fotônica.
– Simpático/Parassimpático: é controlado pelo SNA (sistema nervoso autônomo), de forma a manter e recuperar rapidamente o equilíbrio, isto é feito através de dois subsistemas principais denominado sistema nervoso simpático e sistema nervoso parassimpático. O sistema nervoso simpático atua como um apoio para o corpo durante os momentos de atividades alteradas, enquanto o parassimpático auxilia na retomada a normalidade e no processo de renovação, pode-se dizer que o parassimpático atua como o motor do sistema enquanto o simpático atua como acelerador e freios.
– Sinacitos: estagio de um endobionte.
– Valência: è o grau de estagio de um endobionte.
– Virtual: reprodução sutil de freqüências de ondas.
– Zapper: emissor de freqüência entre 2.5 kHz e 30 kHz, que reproduz as ondas freqüênciais de algumas bactérias destruindo-as.
Abaixo observaremos algumas laminas e imagens respectivas do microscópio de campo escuro, com o sangue vivo. Lembramos que esta técnica original de exame de sangue vivo não é um procedimento diagnóstico para nenhuma doença específica. É mais um teste de seleção para refletir como os terrenos e os hábitos do estilo de vida que podem influenciar a saúde, e onde os ajustes apropriados são necessários dentro destas áreas a fim otimizar a saúde e impedir o início da doença, de acordo com a descoberta, na lamina, de alguns microorganismos. Os problemas de saúde e as circunstâncias degenerativas podem ser impedidos com intervenção nutritiva adiantada e reforçada com o uso de recursos sutis vibracionais, como por exemplo o Pontal Energético.